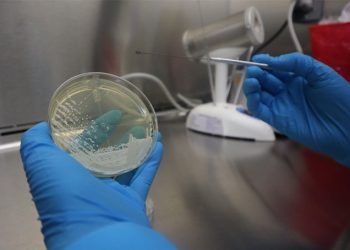

Ministerio de Salud mantiene la alerta epidemiológica por casos de dengue en 12 departamentos
Ciudad de Guatemala, 28 abr (AGN).- El Ministerio de Salud Pública y Asistencia Social (MSPAS), insta a la población a mantener las medidas preventivas para evitar la transmisión del dengue, ...